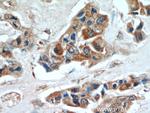
INVS Antibody in Immunohistochemistry (Paraffin) (IHC (P))

Search
Proteintech
INVS Polyclonal Antibody
{{$productOrderCtrl.translations['antibody.pdp.commerceCard.promotion.promotions']}}
{{$productOrderCtrl.translations['antibody.pdp.commerceCard.promotion.viewpromo']}}
{{$productOrderCtrl.translations['antibody.pdp.commerceCard.promotion.promocode']}}: {{promo.promoCode}} {{promo.promoTitle}} {{promo.promoDescription}}. {{$productOrderCtrl.translations['antibody.pdp.commerceCard.promotion.learnmore']}}
产品信息
10585-1-AP
已发表种属
宿主/亚型
分类
类型
抗原
偶联物
形式
浓度
规格
保存条件
运输条件
产品详细信息
This antibody is a rabbit polyclonal antibody raised against part of N-terminus of human INVS. The calculated molecular weight of INVS is 80 kDa, but the modified INVS protein is about 100-110 kDa.
Immunogen sequence: MNKSENLLF AGSSLASQVH AAAVNGDKGA LQRLIVGNSA LKDKEDQFGR TPLMYCVLAD RLDCADALLK AGADVNKTDH SQRTALHLAA QKALRTISTG RI (1-101 aa encoded by BC006370)
靶标信息
This gene encodes a protein containing multiple ankyrin domains and two IQ calmodulin-binding domains. The encoded protein may function in renal tubular development and function, and in left-right axis determination. This protein interacts with nephrocystin and infers a connection between primary cilia function and left-right axis determination. A similar protein in mice interacts with calmodulin. Mutations in this gene have been associated with nephronophthisis type 2. Multiple transcript variants encoding distinct isoforms have been identified for this gene.
仅用于科研。不用于诊断过程。未经明确授权不得转售。